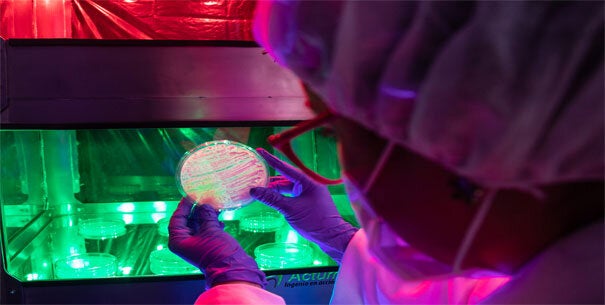
bacteriologa viendo bacterias

Nuestro país asumió el reto y a través del proyecto ‘Trabajando juntos para combatir la resistencia a los antimicrobianos’, financiado por la Unión Europea (UE), y con la asesoría técnica de la Organización Panamericana de la Salud (OPS), la Organización de las Naciones Unidas para la Alimentación y la Agricultura (FAO), la Organización Mundial de Sanidad Animal (OMSA) y el Programa de las Naciones Unidas para el Medio Ambiente (PNUMA), bajo el enfoque de ‘Una salud’, espera consolidar las mejores prácticas en el uso de antimicrobianos y ser un referente regional en la lucha contra esta problemática mundial.
La estrategia se desarrolla teniendo como eje el trabajo multi e interdisciplinar de la Mesa Técnica Intersectorial, de la que hacen parte los Ministerios de Salud y Protección Social (MSPS), Agricultura y Desarrollo Rural (MADR) y Medio Ambiente y Desarrollo Sostenible (MADS); además de sus instituciones adscritas: Instituto Nacional de Salud (INS), Instituto Nacional de Vigilancia de Medicamentos y Alimentos (INVIMA), Instituto Colombiano Agropecuario (ICA) y Corporación Colombiana de Investigación Agropecuaria (AGROSAVIA).
Cada uno participa y aporta desde su experticia, como se puede conocer en el texto ‘Mesa intersectorial sobre RAM, juntos por una salud’.
Este sitio web es uno de los subproductos del proyecto y cuenta con información actualizada sobre la epidemiología de la resistencia antimicrobiana en Colombia, acciones colaborativas, lineamientos nacionales, investigaciones básicas y clínicas, y desarrollos en las áreas de salud humana, sanidad animal, alimentos y medio ambiente, en el marco de la estrategia multisectorial, que podrá ser consultada y ampliada, y servirá de base para generar políticas y definir acciones en todos los niveles.
Algunos contenidos se producen directamente desde la oficina de la OPS en Washington, y otros son desarrollados en Colombia, con el apoyo y asesoría de expertos en cada área de trabajo y los líderes de los grupos focales de cada entidad de la Mesa Técnica Intersectorial, en coordinación con sus líderes de comunicaciones.
Los invitamos a navegar por este universo y a conocer el trabajo que adelanta Colombia, que hoy lo posiciona como uno de los líderes en la región Andina en la lucha contra la problemática de la resistencia antimicrobiana.